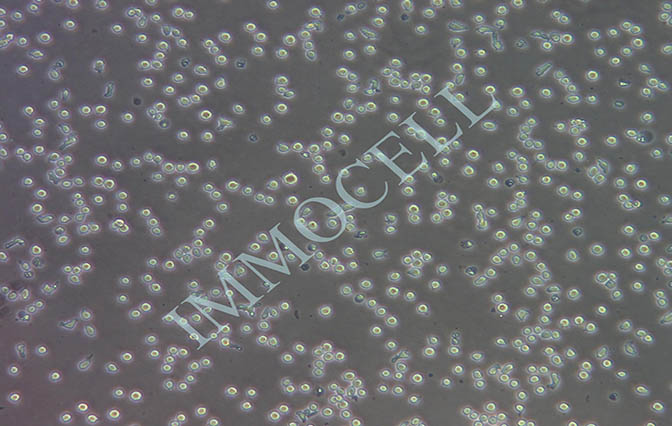
OCI-AML2 人急性髓系白血病细胞

| 注册证号 | 详询 |
| 英文名 | OCI-AML2 人急性髓系白血病细胞 |
| CAS号 | / |
| 数量 | 999 |
| 供应商 | IMMOCELL |
| 肿瘤类型 | 详询 |
| 细胞类型 | 悬浮 |
| ATCC Number | 详询 |
| 品系 | 人源细胞株 |
| 组织来源 | 白血病细胞 |
| 相关疾病 | 详询 |
| 物种来源 | 人 |
| 免疫类型 | 详询 |
| 细胞形态 | 淋巴母细胞样 |
| 是否是肿瘤细胞 | 详询 |
| 器官来源 | 详询 |
| 运输方式 | 顺丰快递 |
| 年限 | 永久 |
| 生长状态 | 正常 |
OCI-AML2 人急性髓系白血病细胞介绍
一、产品基本信息
细胞名称:OCI-AML2,人急性髓系白血病细胞
种属来源:人
组织来源:白血病细胞
细胞形态:淋巴母细胞样
生长特性:悬浮生长
培养基::90%RPMI-1640+10%FBS
生长条件:气相:95%空气+5%二氧化碳;温度:37℃
传代方法:1:2至1:3,每周 3次
冻存条件:无血清冻存液,液氮储存
支原体检测:无
二、细胞培养操作
1)复苏细胞:将含有1 mL细胞悬液的冻存管在 37℃水浴中迅速摇晃解冻,加4 mL培养基混合均匀。在1000 rpm条件下离心3 min,弃去上清液,加1-2 mL培养基后吹匀。然后将所有细胞悬液加入含适量培养基的培养瓶中培养过夜(或将细胞悬液加入10 cm皿中,加入约8 mL培养基,培养过夜)。第二天换液并检查细胞密度。
2)细胞传代:如果细胞密度达80%-90%,即可进行传代培养。
a、将细胞悬液装入无菌离心管中,1000 rpm离心5 min,弃去上清液,补加1-2 mL培养液后吹匀。
b、将细胞悬液按1:2比例分到新的含8 mL培养基的新皿中或者瓶中,置于培养箱中培养。
3)细胞冻存:待细胞生长状态良好时,可进行细胞冻存。下面 T25 瓶为例;
a、收集细胞及细胞培养液,装入无菌离心管中,1000 rpm条件下离心4 min,弃去上清液,用PBS清洗一遍,弃尽PBS,加 1 mL血清重悬细胞,进行细胞计数。
b、根据细胞数量加入无血清细胞冻存液,使细胞密度5×106~1×107/mL,轻轻混匀,每支冻存管冻存1mL细胞悬液,注意冻存管做好标识。
c、将冻存管放入-80℃冰箱,24 h后转入液氮灌储存。记录冻存管位置以便下次拿取。